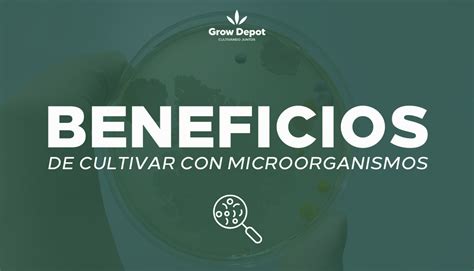

El medio de Cary Blair es una modificación del medio de Stuart, desarrollado para mejorar la preservación y el transporte de microorganismos, especialmente aquellos presentes en muestras fecales. Su diseño se centra en mantener la viabilidad de las bacterias durante el tiempo que transcurre entre la recolección de la muestra y su procesamiento en el laboratorio.

Historia y Desarrollo
Los autores del medio de Cary Blair se percataron de que el glicerofosfato, presente en el medio de Stuart original, podía ser metabolizado por algunas bacterias, generalmente saprófitas o acompañantes. Esto provocaba que estas bacterias enmascararan a las patógenas al aumentar su número. Para solucionar este problema, sustituyeron el glicerofosfato por un tampón inorgánico fosfatado.
Además, se le omitió el azul de metileno, y se aumentó el pH a 8,4.
Composición y Función
El medio de Cary Blair es un medio líquido que contiene:
- Agar-agar, que proporciona una consistencia semisolida.
- Cloruro de calcio, que ayuda a equilibrar el pH.
- Tampon inorgánico fosfatado.
- Componentes que aseguran la reducción del medio.
El pH del medio debe ajustarse a 8,4 ± 0,2.
Este medio está diseñado para mantener el balance osmótico y conservar los microorganismos a un pH idóneo durante el transporte.
Guía De Cómo Utilizar COPAN FecalSwab™ Para Toma de Muestras de Heces Fecales
Aplicaciones
Originalmente, el medio de Cary Blair fue destinado al transporte de microorganismos fecales. Sin embargo, también se utiliza con éxito para el transporte de anaerobios.
Además, se puede utilizar para el transporte de:
- Patógenos Fastidiosos.
- Muestras biológicas.
Consideraciones Adicionales
El tiempo de supervivencia del microorganismo dependerá de la cepa en cuestión.
Es importante procesar las muestras lo antes posible después de la recolección y mientras están en tránsito.
Variaciones
En algunas formulaciones, el azul de metileno se sustituye por carbón vegetal neutro farmacéutico.
Instrucciones de Uso
- Recolectar la muestra.
- Inyectar el material dentro del frasco sin sacar la tapa.
Ventajas
El medio de Cary Blair ofrece varias ventajas, incluyendo:
- Mantiene un ambiente reducido.
- Permite el desarrollo en condiciones anaeróbicas.
- Es útil para el aislamiento y las pruebas de microorganismos.
tags: #cary #blair #medio #de #transporte